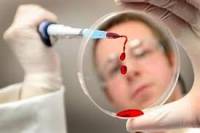

| В Киеве погибла еще одна журналистка |
| Врачи вывели из комы солистку группы «Воровайки» |
| Пропавшая в Свердловской области сотрудница полиции найдена убитой |
 |  |
|
| Главное | Политика | Экономика | Общество | Культура | Происшествия | Шоу-бизнес | Спорт | Технологии |
Новости шоу-бизнесаПодпишитесь на нашу рассылку Наш партнёрЖенская сеть myJulia.ru |
Китайские исследователи скрестили птичий и свиной грипп. Мировое сообщество раскритиковало их за безответственность4.5.2013 11:37 Фото: kiyany.obozrevatel.com Фото: kiyany.obozrevatel.com Китайские исследователи скрестили два вида гриппа - свиной и птичий, вследствие чего получился, по всей вероятности, смертельный для человека вирус. Ученых китайского государства уже осудило мировое научное сообщество, назвав этот эксперимент бессмысленным и слишком опасным. Если новый штамм вируса вырвется из лаборатории, то миллионы людей по всему миру могут пострадать. Занимавший ранее пост главы Королевского общества профессор Оксфордского университета Лорд Мэй сказал: «Они уверяют, что сделали это лишь для того, чтобы помочь разработать вакцину против вируса и тому подобное. Однако, на самом деле, подлинная причина кроется только в том, что они руководствуются слепыми амбициями, которые не имеют абсолютно никакого смысла». Также он назвал это «открытие» страшно безответственным исследованием, так как вирус может покинуть пределы лаборатории и вызвать ужасную пандемию. «Неважно, что вирус пребывает сейчас в лаборатории. По цепочке от человека к человеку он может покинуть ее пределы, и с их стороны это слишком безответственно», - утверждает Лорд Мэй. Это спорное, с точки зрения многих ученых, исследование было организовано под руководством профессора Хуалан Чена.
Комментарии(всего комментариев: 2)[04.05.2013 12:52:08] Написал: anilar круто! "а давайте-ка обогатим уран процентов до двадцати, выточим из него стержень, навесим всяких проводков и посмотрим, что получится... фигасе, как красиво жахнуло! А давайте еще эту петарду вон к той ракете привинтим... ухты, жахнуло у соседей! а что это у нас тут за пробирочки стоят? да мы так, чисто из научного интееса... чейто я закашлял..." [04.05.2013 12:35:53] Написал: Сергей Военная разработка,что тут причитать..такие вещи только для этого и делаются,и государство всегда в курсе. Добавить комментарийДля добавления комментария заполните все поля формы:Смотрите еще:
|
Тайны дняПоиск
ПопулярноеКулинарные рецепты на Поваренке |
||||||||||||||||||||||||||||||||||||||||||||||||||||||||||||
| Главное | Политика | Экономика | Общество | Культура | Происшествия | Шоу-бизнес | Спорт | Технологии |
©2008 Интерновости.Ру, проект группы «МедиаФорт» Редакция сайта: info@internovosti.ru. Общие и административные вопросы: info@mediafort.ru Информация на сайте для лиц старше 18 лет. Свидетельство о регистрации СМИ Эл №ФС77-32298 |
|